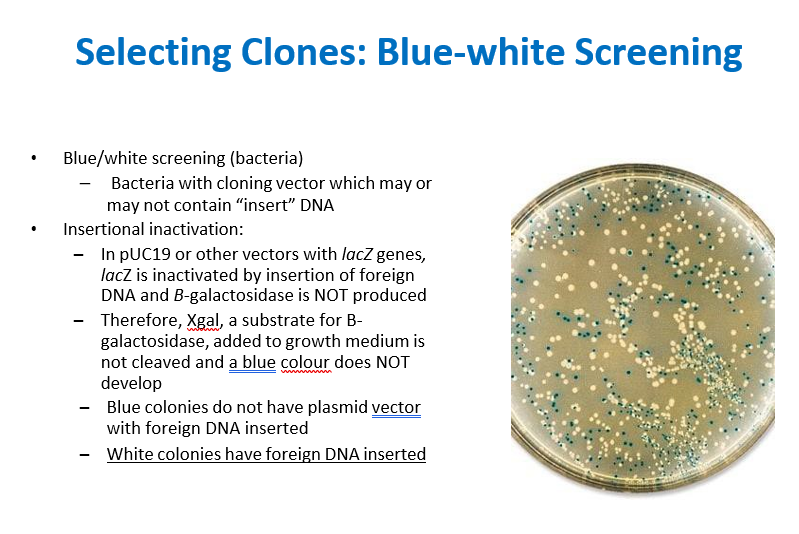

What is polymerase chain reaction (PCR)
-DNA replication in a test tube (in vitro)
-Also called DNA amplification
-Rapid amplification in the number of copies of specific DNA sequences for further analysis i.e. multiplying segments of target DNA up to a billion-fold during amplification
-A thermocycler is an automated PCR machine

What are the steps in PCR amplification

What is reverse transcription PCR (RT-PCR)

What is site-directed mutagenesis
-Easy to obtain 12-40 base DNA oligonucleotides through chemical synthesis
-PCR can be used to obtain gene with specific mutation depending on position of desired change
-If target gene is part of E. coli chromosome or cloned in vector, PCR product can be exchanged through recombination
-Allows any base pair in gene to be changed
-Progeny are screened with PCR and DNA sequencing to detect mutation
-Can be used to manipulate proteins to test importance of specific amino acids at specific sites

Explain agarose gel electrophoresis
- Separates DNA molecules based on size and charge
- Nucleic acids migrate through the gel towards the positive electrode due to their negatively charged phosphate groups
- Small molecules move faster than large ones

Describe nucleic acid probing (hydridization)

What are southern blots and how can you interpret them

What are northern blots
Focused on RNA

Describe cloning
Movement of a gene from original source to small and manipulable genetic element (vector)
– Results in recombinant DNA (molecule containing DNA from different sources)
– Gene can be manipulated
– Cloned DNA replicated in appropriate host
– Foundation for much of genetic engineering

What are the enzymes used for cloning?

Describe EcoR1

What are restriction endonucleases?

What is the purpose of DNA modification

What are cloning vectors

Why are plasmids used as cloning vectors

Describe the function of pUC19

Explain molecular cloning using restriction endonucleases

What is blue-white screening
Explain cassette mutagenesis and gene disruption

How are clones detected with correct DNA inserts

What are common hosts for cloning

How are foreign genes expressed in bacteria

Explain the T7 expression system

What are other features of expression vectors



